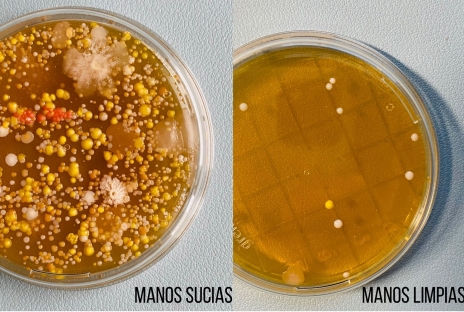
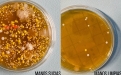

|
Colegio Nazaret Oviedo 150 años "acompañándoTe" ¿Te unes? |
 |
 |
|
![]() Avda. de Valentín Masip, nº 31.
Avda. de Valentín Masip, nº 31. ![]() + 34 985 23 19 00
+ 34 985 23 19 00 ![]() info@colegionazaret.es
info@colegionazaret.es
EL COVID SE COMBATE DESDE EL COLEGIO NAZARET
Cuando aprender se convierte en un juego, todo es más fácil. Ese planteamiento, que alienta la gamificación en el aula, sirve tanto para los contenidos lectivos puros, ya sean matemáticas o lecciones de historia, como a la hora de enseñar a los alumnos determinadas pautas de comportamiento.
El colegio Nazaret de Oviedo, que ya tiene experiencia integrando dinámicas propias del juego “Among Us” en sus clases, ha desarrollado una actividad lúdica para reforzar las pautas de seguridad de los alumnos de tercer curso de Educación Primaria ante la pandemia de coronavirus. Una actividad en la que los niños se convirtieron en auténticos detectives buscando claves para derrotar al temido Covid-19.
Las maestras del centro prepararon un “breakout” (una actividad lúdica con una dinámica de resolución de enigmas similar a la que se puede encontrar en las populares “Escape Room”) en el que los niños debían resolver una serie de misiones, cada una de ellas en un país diferente, y todas referentes a la lucha contra el virus. Al resolver los enigmas y rompecabezas que se les planteaba en cada prueba, los alumnos iban viendo los porqués de cada una de las medidas de seguridad que se han ido implementando para tratar de frenar la expansión del Covid-19.
El tramo final del “breakout” sintetiza con precisión la naturaleza de la actividad. Al desbloquear la última medida de seguridad, resueltos ya todos los enigmas anteriores, se trabajaba con los alumnos la necesidad de lavarse las manos. Las maestras facilitaron a los alumnos unas placas de contacto, a través de las cuales se pueden observar las bacterias presentes en cualquier superficie, incluidas las propias manos de los niños.
Cada alumno tomó muestras de sus manos antes y después de lavárselas con agua y jabón, y dejaron ambas placas reposar unos días. Al cabo del tiempo, los microorganismos comenzaron a crecer, y los niños pudieron observar a simple vista la diferencia: en las placas con las muestras tomadas antes de lavarse las manos, aparecían infinidad de motitas. mientras que las que tenían las muestras de las manos limpias permanecían prácticamente igual.
Al final de la actividad, los alumnos recibieron un diploma que los identifica como “Covid Fighters”, por haber superado todos los retos que les plantearon sus maestras.
“Los niños están informados y comprenden la importancia de mantener las medidas de seguridad, pero nos inquieta que durante las vacaciones de Navidad se puedan descuidar. Por eso, hemos querido reforzar su responsabilidad a través del juego”, explica María Nieves Sainero, tutora de 3ºA y una de las impulsoras de la experiencia.
“Parecía que teníamos las manos limpias, pero estábamos equivocados. Es muy importante lavarse muy bien las manos”, afirmaba María Jesús González Seban, una de las alumnas que participó en la actividad. “La experiencia fue muy divertida y nos dimos cuenta de lo necesario que es respetar las medidas de seguridad para que el virus desaparezca”, añadía su compañero Unai González Álvarez.
“Fue una oportunidad muy enriquecedora y significativa el poder hacer visible lo invisible, concienciándolos de lo importante que es tener una buena higiene”, concluía Ana Durán, tutora de 3ºB.
Fecha:
Viernes, 18 Diciembre 2020
Enlaces
Contacto
Avda. de Valentín Masip, nº 31
33013 - OVIEDO
Tfno.: 985 23 19 00 - Fax.: 985 27 07 19
Contacto: info@colegionazaret.es
Education - This is a contributing Drupal Theme
Design by WeebPal.
Design by WeebPal.